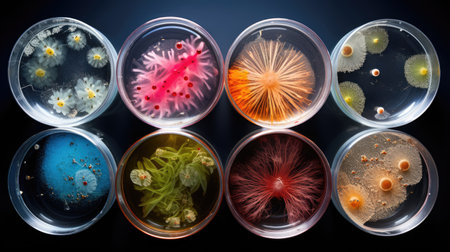

素材 - Background with mixed bacteria colonies, fungi or microbes in various petri dish. Growing cultures of microorganisms
作品情報
Background with mixed bacteria colonies, fungi or microbes in various petri dish. Growing cultures of microorganisms
- ID:210568672
- 作品種別:
- 作者名:eireen
キーワード
- analysis
- bacillus
- background
- bacteria
- bacterial
- bacteriology
- biochemistry
- biological
- biology
- biotechnology
- cell
- chemical
- chemistry
- clinic
- clinical
- diagnostics
- disease
- dish
- dna
- equipment
- experiment
- glass
- glassware
- health
- hospital
- hygiene
- illness
- infection
- isolated
- lab
- lab glassware
- laboratory
- macro
- medical
- medicine
- microbiology
- microorganism
- microscope
- organism
- petri
- plate
- research
- sample
- science
- scientific
- scientist
- technology
- test
- virus
類似作品
Backgrounds of ...
Air bubbles ins...
Microscopic vie...
The mesmerizing...
Backgrounds of ...
Abstract ink te...
Backgrounds of ...
Backgrounds of ...
Backgrounds of ...
Close up petri ...
Backgrounds of ...
Texture of natu...
Backgrounds of ...
Explore the uns...
Backgrounds of ...
Bacterial and m...
white and purpl...
Abstract ink te...
Backgrounds of ...
Textures and Co...
A colorful abst...
Diverse colorfu...
Backgrounds of ...
Backgrounds of ...
3d rendered ill...
Close-up of a c...
Backgrounds of ...
Characteristics...
natural mold on...
Bacterial colon...
microbial cultu...
Colonies of dif...
Various types o...
Microscopic bac...
close-up, micro...
abstract backgr...
Paint stream dr...
Backgrounds of ...
Colony characte...
Intricate micro...
Microscopic wor...
Abstract brown ...
AI Generated. c...
Old wall with c...
Backgrounds of ...
microbial cultu...
Shimmer bubbles...
green algae pon...
Backgrounds of ...